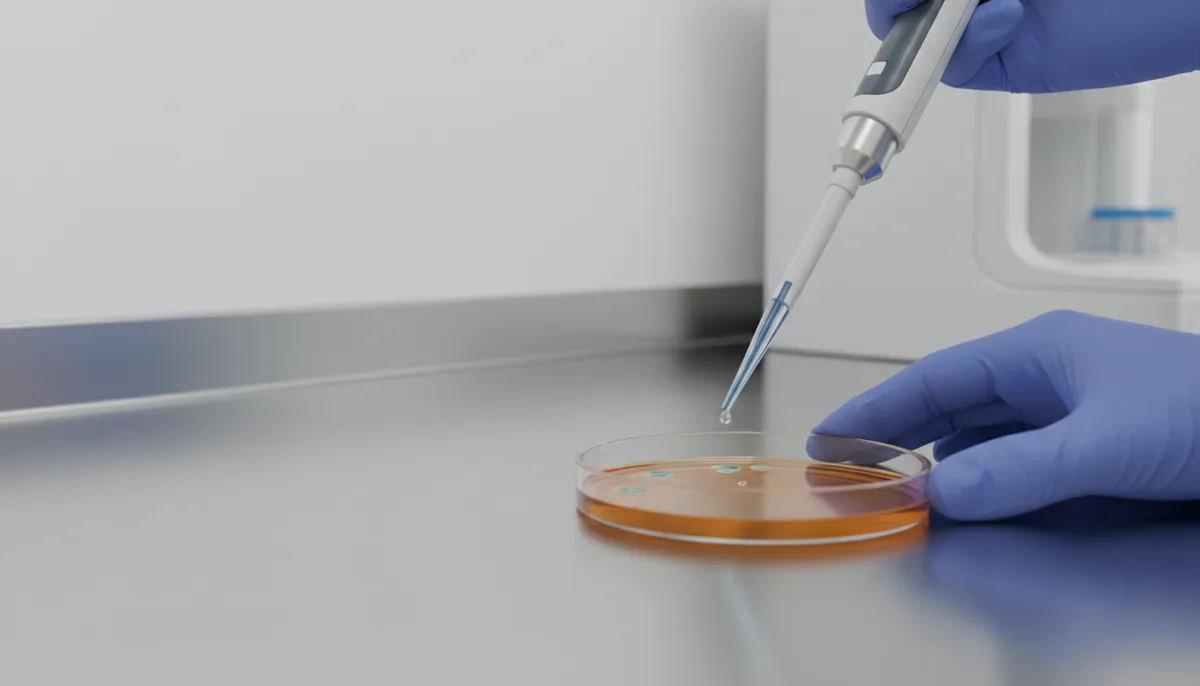
Test microbiologique : méthodes, coûts 2026 et choix du kit ou laboratoire

Test microbiologique : méthodes, coûts 2026 et choix du kit ou laboratoire
Test microbiologique : grille tarifaire 2026 par secteur
Le budget consacré aux tests microbiologiques dépend du secteur, des paramètres recherchés et du choix entre un kit ou un laboratoire.
| Secteur | Paramètre recherché | Méthode | Coût HT (2026) | Délai | Type de test |
|---|---|---|---|---|---|
| Agroalimentaire | Flore totale | Kit (ex : 3M Petrifilm) | 25-40 € | 24-48 h | Autocontrôle |
| Agroalimentaire | Salmonella | Laboratoire COFRAC | 80-120 € | 72 h | Analyse réglementaire |
| Agroalimentaire | Listeria monocytogenes | Laboratoire COFRAC | 90-130 € | 5-7 jours | Analyse réglementaire |
| Eau | Escherichia coli | Kit (ex : Colilert) | 30-50 € | 18-24 h | Autocontrôle |
| Eau | Légionelles | Laboratoire COFRAC | 150-250 € | 7-10 jours | Analyse réglementaire |
| Cosmétique | Charge microbienne totale | Laboratoire COFRAC | 100-200 € | 48-72 h | Analyse réglementaire |
| Pharmaceutique | Stérilité | Laboratoire COFRAC | 200-300 € | 5-7 jours | Analyse réglementaire |
Pour un artisan fromager, le coût mensuel des tests oscille entre 100 € HT (kits internes) et 500 € HT (analyses en laboratoire). Les traiteurs doivent prévoir un budget similaire, avec des tests systématiques pour chaque lot de plats cuisinés. Ces dépenses sont éligibles aux aides à la création d’entreprise.
Méthodes de test microbiologique : kits vs laboratoires
Les professionnels disposent de deux options pour réaliser des tests microbiologiques : les kits de test (autocontrôle) et les laboratoires accrédités (analyses réglementaires).
Les kits permettent de réaliser des tests en interne, sans compétences spécifiques, ce qui les rend idéaux pour les autocontrôles fréquents et les résultats rapides. Parmi les solutions disponibles, le 3M Petrifilm est couramment utilisé pour le dénombrement de la flore totale, d’E. coli et des coliformes, avec un coût variant entre 25 et 40 € HT et des résultats obtenus en 24 à 48 heures. Le Colilert est quant à lui adapté à la détection d’E. coli et des entérocoques dans l’eau, pour un tarif de 30 à 50 € HT et des résultats en 18 à 24 heures. Enfin, l’ATP-métrie permet un contrôle rapide de l’hygiène des surfaces, avec des résultats en 15 minutes pour un coût de 15 à 40 € HT.
Cette méthode présente plusieurs avantages, notamment un coût réduit (20 à 80 € HT par test) et des délais rapides (de 15 minutes à 48 heures). Elle est particulièrement adaptée aux contrôles internes fréquents. Cependant, les kits ont une précision limitée et comportent un risque de faux négatifs. Autre point : ils ne sont pas valables pour les analyses réglementaires.
Les laboratoires accrédités COFRAC selon la norme ISO 17025 sont obligatoires pour les analyses réglementaires. Ils garantissent la fiabilité des résultats et la conformité aux normes grâce à des méthodes variées. La culture classique, conforme aux normes ISO 4833 et ISO 6579, permet le dénombrement de la flore totale ou la recherche de pathogènes comme Salmonella. La PCR en temps réel offre une détection rapide des pathogènes, avec des résultats disponibles en 4 à 24 heures.
Les avantages des laboratoires sont nombreux : résultats fiables et reconnus par les autorités, adaptés aux analyses réglementaires (comme le règlement CE 2073/2005) et accompagnement en cas de non-conformité. En revanche, leur coût est plus élevé (80 à 300 € HT par analyse) et les délais sont plus longs (de 48 heures à 10 jours).
Pour les denrées alimentaires, la norme ISO 21528 combine culture et méthodes rapides. Un laboratoire comme Analytice propose des analyses par PCR pour 85 € HT en 24 heures.
Quels secteurs doivent réaliser des tests microbiologiques ?
Les tests microbiologiques sont obligatoires pour plusieurs secteurs, encadrés par des réglementations strictes.
Le secteur agroalimentaire est soumis au règlement CE 2073/2005, qui impose des autocontrôles réguliers pour garantir la sécurité des denrées alimentaires. Les paramètres obligatoires incluent Salmonella, notamment pour les volailles, les œufs et les produits carnés, ainsi que Listeria monocytogenes, particulièrement surveillée dans les fromages, les poissons fumés et les plats cuisinés. Escherichia coli est également un paramètre clé pour les produits laitiers et la charcuterie.
La fréquence des tests varie selon les activités. Les fromagers doivent réaliser au moins quatre analyses par mois, tandis que les traiteurs doivent tester chaque lot de plats cuisinés. Les producteurs de viande sont tenus d’effectuer deux analyses mensuelles.
Le secteur de l’eau est régi par le code de la santé publique et la directive européenne 98/83/CE. Les paramètres à contrôler incluent Escherichia coli, indicateur de contamination fécale, les entérocoques, également liés à une contamination fécale, et les légionelles, particulièrement surveillées dans les réseaux d’eau chaude sanitaire.
La fréquence des tests dépend du type d’eau. Pour l’eau potable, les petits réseaux doivent réaliser une analyse par mois, tandis que l’eau en bouteille nécessite un test par lot. Les réseaux d’eau chaude doivent être contrôlés trimestriellement pour les légionelles.
Pour en savoir plus, consultez notre guide sur l’analyse microbiologique de l’eau.
Les secteurs cosmétique et pharmaceutique doivent se conformer aux bonnes pratiques de fabrication (BPF) et aux normes ISO 22716 pour les cosmétiques ou ICH Q7 pour la pharmacie. Les tests obligatoires incluent la charge microbienne totale pour les cosmétiques et la stérilité pour les produits pharmaceutiques injectables.
La fréquence des tests est stricte : un test par lot pour les cosmétiques et un test par lot pour les produits pharmaceutiques, avec des contrôles renforcés pour les produits stériles.
Cas pratique : test microbiologique pour un artisan fromager vs un producteur d’eau
Artisan fromager
Un fromager affineur doit contrôler ses produits quatre fois par mois pour se conformer au règlement CE 2073/2005. Il réalise deux analyses hebdomadaires pour détecter Listeria monocytogenes, confiées à un laboratoire COFRAC comme Eurofins, avec une méthode PCR, pour un coût mensuel de 360 € HT. Une analyse hebdomadaire pour Salmonella est effectuée par Carso en utilisant la culture classique, pour un coût de 100 € HT. Enfin, une analyse hebdomadaire d’E. coli est réalisée en interne avec des kits 3M Petrifilm, pour un coût de 40 € HT. Le budget mensuel total s’élève à 500 € HT, soit un budget annuel de 6 000 € HT, éligible aux aides à la création d’entreprise.
Producteur d’eau en bouteille
Un producteur d’eau minérale doit réaliser un test par lot pour garantir la conformité au code de la santé publique. Il effectue quatre analyses par mois pour détecter E. coli, confiées à un laboratoire COFRAC comme Analytice, avec une méthode PCR, pour un coût mensuel de 200 € HT. Quatre analyses supplémentaires sont réalisées pour les entérocoques, via Eurofins en culture classique, pour un coût de 200 € HT. Enfin, deux analyses par mois pour la flore totale sont effectuées en interne avec des kits Colilert, pour un coût de 60 € HT. Le budget mensuel total s’élève à 460 € HT, soit un budget annuel de 5 520 € HT.
Pour optimiser vos coûts, comparez les offres des laboratoires et privilégiez les kits pour les contrôles internes. Consultez notre guide sur l’analyse microbiologie alimentaire.


